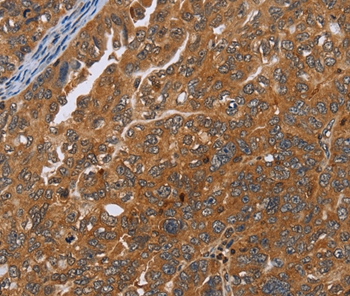

Immunohistochemistry of paraffin-embedded Human ovarian cancer tissue using ADAMTS15 Polyclonal Antibody at dilution 1:40
ADAMTS15 Polyclonal Antibody
E-AB-10171
Product group Antibodies
Overview
- SupplierElabscience
- Product NameADAMTS15 Polyclonal Antibody
- Delivery Days Customer12
- Applications SupplierELISA IHC
- CertificationResearch Use Only
- Concentration0.6mg/ml
- Scientific DescriptionThis gene encodes a member of the ADAMTS (a disintegrin and metalloproteinase with thrombospondin motifs) protein family. ADAMTS family members share several distinct protein modules, including a propeptide region, a metalloproteinase domain, a disintegrin-like domain, and a thrombospondin type 1 (TS) motif. Individual members of this family differ in the number of C-terminal TS motifs, and some have unique C-terminal domains. The protein encoded by this gene has a high sequence similarity to the proteins encoded by ADAMTS1 and ADAMTS8.
- UNSPSC12352203